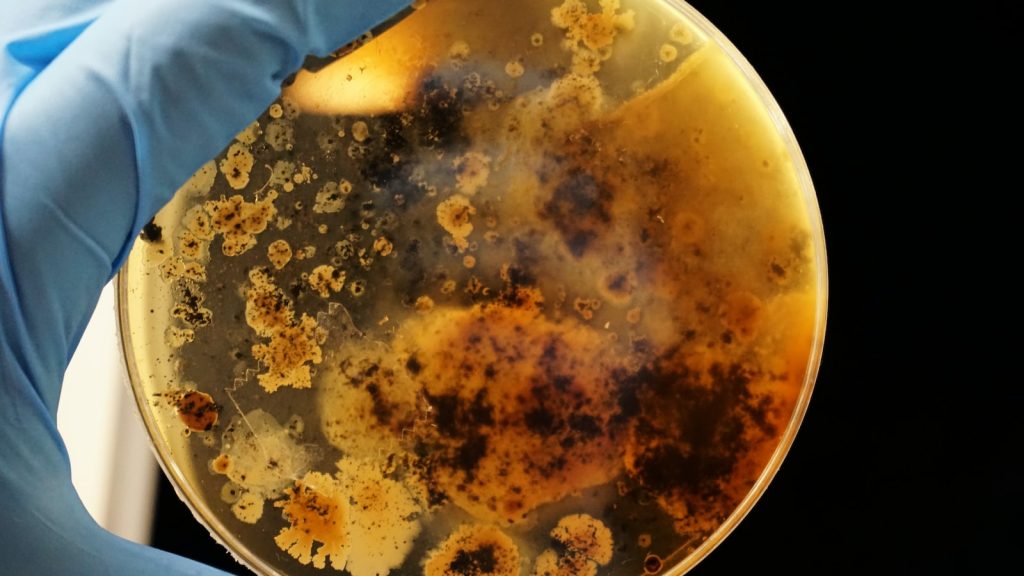
Tarta de queso con agar agar

Contenido
- 1. Qué es la tarta de queso con agar agar y cómo se prepara
- 2. Los ingredientes necesarios para hacer una tarta de queso con agar agar
- 3. Beneficios del agar agar en esta receta de tarta de queso
- 4. Pasos para preparar la mezcla de queso y agar agar correctamente
- 5. Consejos para decorar y servir la tarta de queso con agar agar
- 6. Otras variantes de la receta de la tarta de queso con agar agar
- 7. Posibles errores al cocinar esta tarta y cómo solucionarlos
- 8. Recomendaciones para disfrutar al máximo de esta deliciosa tarta de queso con agar agar
- Deliciosa tarta de queso muy fácil y rápida de preparar
- Óptima para disfrutar en tus postres, meriendas y fiestas de cumpleaños
- Conservar en lugar fresco y seco
- Una vez preparado, conservar refrigerado
La tarta de queso es un postre que ha ganado popularidad en muchos rincones del mundo. Sin embargo, existen diversas formas de prepararla y darle un toque original. Si eres un apasionado de los postres y te encanta experimentar con diferentes ingredientes, debes probar la tarta de queso con agar agar. Este ingrediente es de origen vegetal y tiene propiedades gelificantes, por lo que resulta ideal para dar consistencia a esta deliciosa tarta. En esta ocasión, te presentamos una receta fácil y rápida para que puedas preparar en casa una deliciosa tarta de queso con agar agar. ¡Anímate a probarla!
1. Qué es la tarta de queso con agar agar y cómo se prepara
La tarta de queso con agar agar es una versión vegana y saludable de la clásica tarta de queso. El agar agar es un espesante natural obtenido de algas marinas. Aquí te presentamos la receta para que puedas prepararla en casa:
- Ingredientes:
- 1 taza de anacardos remojados durante 6 horas
- 1/2 taza de sirope de agave
- 1/4 taza de jugo de limón
- 1/4 taza de aceite de coco derretido
- 2 cucharaditas de agar agar en polvo
- 1 cucharadita de extracto de vainilla
- 1 pizca de sal
- 2 tazas de fresas frescas
- 1/2 taza de agua
- 2 cucharadas de sirope de agave
- Preparación:
- En una batidora, mezcla los anacardos, el sirope de agave, el jugo de limón, el aceite de coco, el agar agar, la vainilla y la sal hasta que obtengas una mezcla suave.
- Vierte la mezcla en un molde para tarta y deja enfriar durante 1 hora.
- Para la salsa de fresas, coloca las fresas, el agua y el sirope de agave en una olla y cocina a fuego medio durante 10 minutos.
- Una vez la tarta de queso haya enfriado, vierte la salsa por encima y decora con fresas.
2. Los ingredientes necesarios para hacer una tarta de queso con agar agar
Puede que no lo sepas, pero puedes hacer una deliciosa tarta de queso usando el agar agar como ingrediente principal. Si no eres vegano o vegetariano, es posible que nunca hayas oído hablar del agar agar, pero se trata de un espesante natural y saludable muy utilizado en la cocina oriental. A continuación, te mostramos los ingredientes que necesitas para hacer una tarta de queso con agar agar.
- 1 taza de queso crema
- 3 tazas de leche de almendras
- 1/2 taza de azúcar orgánica
- 1 1/2 cucharadas de agar agar en polvo
- 1 cucharada de extracto de vainilla
- Para la base:
- 1 taza de galletas trituradas
- 1/4 taza de mantequilla vegana derretida
En primer lugar, debes preparar la base de la tarta mezclando las galletas trituradas con la mantequilla vegana derretida. Pon la mezcla en el fondo de un molde para tartas y déjalo enfriar en la nevera mientras preparas el resto de la tarta. Luego, mezcla el queso crema con la leche de almendras, el azúcar, el agar agar y la vainilla en una olla y cocina a fuego medio, removiendo constantemente, hasta que el agar agar se disuelva completamente.
Cuando la mezcla esté lista, viértela sobre la base de galletas y deja enfriar en la nevera durante al menos 2 horas antes de servir. ¡Disfruta de tu deliciosa tarta de queso con agar agar!
3. Beneficios del agar agar en esta receta de tarta de queso
El agar agar es un ingrediente muy utilizado en la alimentación vegetariana y vegana por su capacidad de gelificar y por ser una alternativa a la gelatina animal. En esta receta de tarta de queso, el agar agar se utiliza para que la tarta cuaje y mantenga su forma, sin la necesidad de añadir gelatina animal.
Además, el agar agar tiene otros beneficios nutricionales, como su alto contenido de fibra soluble que ayuda a regular el tránsito intestinal, así como su contenido en minerales como el hierro, calcio y fósforo.
- Ayuda a mantener una buena digestión gracias a su alto contenido en fibra.
- Alternativa a la gelatina animal, lo hace ideal para dietas vegetarianas y veganas.
- Aporta minerales importantes como el hierro, calcio y fósforo.
4. Pasos para preparar la mezcla de queso y agar agar correctamente
Para preparar la mezcla de queso y agar agar de manera correcta, es importante seguir los siguientes pasos:
- Primero, mezcle los ingredientes secos en un tazón aparte.
- Agregue la leche y el queso a la mezcla seca y bata hasta que estén completamente combinados.
- Añada el agar agar a la mezcla y mezcle bien para garantizar una consistencia uniforme.
Es fundamental prestar atención a la cantidad adecuada de agar agar. Si se agrega demasiado, la mezcla resultará en una textura demasiado firme. Si se agrega muy poco, la mezcla no se solidificará adecuadamente. ¡Experimente un poco hasta encontrar la cantidad perfecta para su receta!
5. Consejos para decorar y servir la tarta de queso con agar agar
La tarta de queso con agar agar es una opción perfecta para aquellos que buscan una alternativa vegana o vegetariana. Aquí te damos algunas recomendaciones para decorar y servir esta deliciosa tarta:
- Usa frutas frescas: Agrega color y sabor a tu tarta de queso con agar agar utilizando frutas frescas como fresas, moras o kiwi. Coloca las frutas en la parte superior para dar un toque extra de sabor.
- Prepara una base crujiente: Si deseas agregar una textura crujiente a tu tarta, prepara una base con galletas trituradas y mantequilla derretida. Deja enfriar la base en el refrigerador antes de verter la mezcla de agar agar y queso.
- Sirve fría: Es importante que la tarta de queso con agar agar esté fría al momento de servirla para que tenga la textura adecuada. Déjala en el refrigerador durante al menos dos horas antes de servir.
Estos consejos te ayudarán a impresionar a tus invitados con una deliciosa tarta de queso con agar agar. ¡Explora diferentes sabores y opciones de decoración para encontrar tu favorita!
6. Otras variantes de la receta de la tarta de queso con agar agar
Uno de los ingredientes más versátiles en la cocina vegetariana es el agar agar, un sustituto a la gelatina que se extrae de las algas. Además de su calidad saludable, se puede utilizar para crear diferentes recetas de postres. A continuación, presentamos tres variantes de la receta de tarta de queso con agar agar para que pruebes y disfrutes.
– Tarta de queso con agar agar y fresas: Añade a la receta de tarta de queso con agar agar, trozos de fresas naturales y colócalos en la parte superior antes de ponerla en la nevera. Decora con fresas enteras.
– Tarta de queso y chocolate: Agrega a la receta convencional de tarta de queso con agar agar, trozos de chocolate negro y derretido. Puedes optar por colocar una capa de chocolate después de la mezcla de queso y antes de ponerla en la nevera.
– Tarta de queso con agar agar y frutas del bosque: En una mezcla de queso fresco con agar agar añade un preparado de frutas del bosque (fresas, arándanos, zarzamoras o moras). Decora con esta misma mezcla.
¡A deleitarse con estas magnificas recetas de tarta de queso con agar agar!
7. Posibles errores al cocinar esta tarta y cómo solucionarlos
- La tarta se ha quedado cruda por dentro.
- Comprueba que tu horno está en la temperatura correcta.
- No demasiado batido.
- Prueba a reducir la cantidad de líquido.
- La tarta se ha quemado por arriba.
- Coloca papel de aluminio encima.
- No tengas el horno demasiado caliente.
- Espolvorea un poco de azúcar sobre la tarta.
- La tarta no ha subido lo suficiente.
- Comprueba que tus ingredientes estén frescos y en la cantidad correcta.
- Bate los ingredientes de la mezcla correctamente.
- Comprueba que el horno está a la temperatura correcta.
8. Recomendaciones para disfrutar al máximo de esta deliciosa tarta de queso con agar agar
- Conserva la tarta en la nevera después de servirla para mantenerla fresca y firme.
- Para darle un toque distinto, agrega frutas frescas al servirla, como fresas, arándanos o kiwi.
- Si prefieres una textura más suave y cremosa, puedes utilizar menos agar agar para la preparación.
- Si no tienes moldes individuales, también puedes preparar esta tarta en un molde redondo y decorarla con frutas y chocolate rallado.
No te pierdas la oportunidad de probar esta exquisita tarta de queso con agar agar y sorprender a tus invitados con una opción saludable y deliciosa.
¡No esperes más! ¡La mejor manera de ahorrar en tus compras!
Los siguientes productos te podrían interesar:
- Deliciosa tarta de queso muy fácil y rápida de preparar
- Óptima para disfrutar en tus postres, meriendas y fiestas de cumpleaños
- Conservar en lugar fresco y seco
- Una vez preparado, conservar refrigerado
- Tarta de queso Donostiarra
- Elaborada de manera artesanal
- Sin conservantes
- Con un sabor dulce
- De textura suave
- Ideal para toda la familia
- Conservar a -18ºC
Última actualización el 2026-03-31 / Enlaces de afiliados / Imágenes de la API para Afiliados